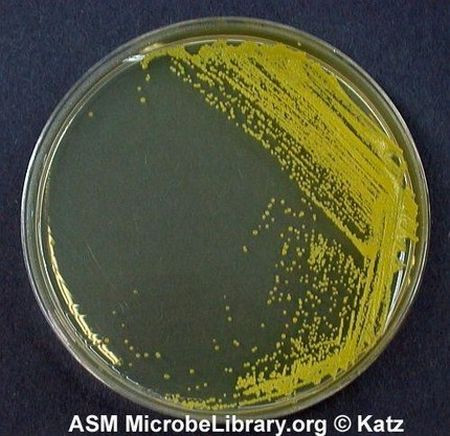
1912340991774478269.jpg 1912340991774478269.jpg

第七回
冰眸望月,一身永劫一身罪
火羽翔空,半是相恨半是情
请不要吐槽标题谢谢。
这一回就让我们谈谈永夜抄里面最是冤家的一对:蓬莱山NEET和藤原蘑菇。
(说来最早听到永夜抄的时候,我第一耳朵听的是“东方母夜叉”;然后那个玩游戏的哥们竟然默然点了点头……游泳池也是我的第一作,说来也感情深,这几次都是YYC的,多包涵……)
说来上次看到一个老师和蘑菇的漫画,这张后入式的纹路实在是莫名地戳中我的萌点……漫画也不错,建议大家去看看。

那咱们还是从典故说起。典故实在是最有意思的事情了~~~~~
蘑菇的典故上次介绍过一点,这次就不专门提,直接来辉夜大人的好了。
蓬莱山辉夜,这个角色取材自日本著名的《竹取物语》中的主人公,辉夜姬。

这就是古人心中的美女。有时候我在想,如果我有古人的审美观,我一定是生活在天堂中……
《竹取物语》据说是日本最早的物语文学,其故事凄美婉约,充满了清丽雅致的日本古典美感与看地上所有人都不顺眼的找抽精神,联系到其创作年代(公元806年到922年平城天皇到醍醐天皇朝,说来这个天皇一定很喜欢喝酒)不难看出,《竹取物语》完美地表现了自中世纪到文艺复兴之间将近一千年间人类动不动就找自己别扭的自嘲精神,以及对另外一个完美世界的向往。

故事呢,大概是这样的:
有一天,一个老爷子去砍竹子,发现一个竹子会发光。他很好奇,打开一看,里面有一个小孩子。那本着天上掉下萝莉不捡白不捡的心态,老爷子把孩子捧在手里带了回家。
嗯,以后大家看到发光的竹子,请一定要记得把它带回家。说不定里面有萝莉哦。
……这么超现实的东西,不可能发生的啦,大家不要当真。

……这……

双灯联体造型,高的是落地照明装饰灯,矮的是应急灯。灯的外壳是高聚合耐高温塑料材料,LED冷光源安装在竹节处;应急灯含电池,可拆下自由使用,也可以安装在底座上充电并发光。该造型方案发扬原设计竹的元素,清秀挺拔,凸显竹子的气质。
……就差只售998了。只要998,单身萝莉捧回家。
……这个世界是不真实的啊啊啊啊啊啊啊啊!!!!!!

咳,总之,老爷子把小女孩捧回了家,交给了老奶奶,放在筐里培养。
嗯,幸好不是在培养皿里培养,不然就和我的专业对口了……
Whatever……
老头到三室户地方去请来一个叫斋部秋田的人,给她起名字。秋田给她取名为“嫩竹的辉夜姬”。也可以写作“辉映姬”,意思是夜间也光彩照人。取了名字后,老人大办筵席,清了各种各样的歌舞人来表演。附近的人家不论男女老少,都被请来参加宴会,一直热闹了三天。
老爷子自那以后,每次一砍竹子,里面都盛满了黄金。于是很快变了富翁。
对这种既得了萝莉又赚钱赚钱的炫耀帝,自然是不能容忍的,这对于我们这些娶了五指姑娘为妻的人实在是太不公平了!想想我们都是……

于是应人民群众的期待,终于出现了秘之战队:NB Ranger!!

他们五个分别是:
皇子:石竹皇子(原型:多治比岛)
皇子:车持皇子(原型:藤原不比等,蘑菇他爹)
右大臣:阿部御主人(原型:阿倍御主人)
大纳言:大伴御行(原型大伴御行)
中纳言:石上麻吕(原型:石上麻吕)
官位分别是:
石作皇子--左大臣正二位多治比真人岛(624--701年)
车持皇子--大纳言正三位藤原朝臣不比等(659--720年)
右大臣阿部御主人--右大臣从二位阿部朝臣御主人(635--703年)
大纳言大伴御行--大纳言正二位大伴宿弥御行(646--701年)
中纳言石上麿足--大纳言正三位石上朝臣麻吕(640--717年)
辉夜姬本着玩死人不偿命的工作方针,给哥几个分配了不可能的任务,分别是:佛前的石钵(石竹皇子,难题「仏の御石の钵 -砕けぬ意志-」、神宝「ブディストダイアモンド」);蓬莱的玉枝(车持皇子,难题「蓬莱の弾の枝 -虹色の弾幕-」、神宝「蓬莱の玉の枝 -梦色の郷-」);火鼠的皮裘(阿倍御主人,难题「火鼠の皮衣 -焦れぬ心-」、神宝「サラマンダーシールド」)龙首的宝珠(大伴御行,难题「龙の颈の玉-五色の弾丸-」、神宝「ブリリアントドラゴンバレッタ」);燕子的子安贝(石上麻吕,难题「燕の子安贝 -永命线-」、神宝「ライフスプリングインフィニティ」)。
这玩意明摆着是扯淡啊,不愿意嫁就算了,别这么玩哥们啊……给张好人卡多少也有点安慰啊……

至少我们还可以……

对于不可能完成的任务,这五位自然是非常完美地没有完成。进而这件事惊动了皇上大人,竟然连天皇都忍不住跃跃欲试了,竟然每天写骚扰短信!
对于这种家伙,辉夜姬那自然是……
辉夜姬也常写优美的回信给他。——《竹取物语》(云南人民出版社)
……果然皇帝是不一样的么……但是不管怎样,辉夜姬也算是一视同仁地没有嫁。
所以其实皇帝也没什么办法啦……

突然有一天!辉夜姬变得异常忧愁起来。老人心想是不是(大姨妈来了)有什么特殊的事情呢?本着(兽父)父亲的立场和原则,老人关心地一再询问。最后,辉夜姬说出了实话:
其实我是外星人,是从(M78)月亮来的。
……

马萨卡……

哈哈哈外星人啊哈哈哈嗯老头子我很能接受毕竟这么萌的少女不可能是土生土长的地球人嘛哈哈哈哈哈……
才怪啊……

于是老头子第一时间采取了行动,联合皇帝大人,准备阻止那些来把辉夜姬接回月球的使徒。
自然天皇大人配备了比较优秀的装备,然而在敬爱的使徒面前,一切都是渣渣。

辉夜姬则依依不舍地给皇上大人写了封信,给老爹留了不死之药。而老爹丢了女儿,茶不思饭不想,药也不想要,转交给皇帝。皇上大人则对了一首诗,就将不死之药投进了不死之山——富士山。从那以后,富士山就从未停止喷烟。
《竹取物语》在日本的影响力,大概就和牛郎织女在中国的影响力一样大,号称是“小说之祖”。从最早称为“赫奕姬物语”,到“竹取的赫奕姬”,到“竹取翁物语”,最终简称成“竹取物语”。在平安时期出现平假名之后,《竹取物语》便出现了平假名与汉文间杂的版本,由此向前推断,认为可能存在汉文本的《竹取物语》故事,经平假名改写,故事上有一定的改动与加工。又因其文字间含有不少本出中国神仙思想与佛教思想的字句和词眼(“蓬莱”、“昙花”等),于是有人认为可能确实存在来源自中国的素材原本。
而在1954年,我国民俗学专家学者深入青藏地区采集民族神话与故事,在四川阿坝藏族自治区收集到相当数量的传说故事。其中有一则故事名为《斑竹姑娘》,其大体情节与《竹取物语》十分类似:
《竹取》女主人公自竹筒出生;《斑竹姑娘》女主人公也同样自竹筒出生。《竹取》女主人公面对的5个求婚者都是贵公子;《斑竹姑娘》女主人公遇到的5个求婚者也都是有权势的少年。两个故事都同样由女主人公向求婚者分别提出一项难题,进行考验,最后一一拒绝,求婚失败。
《竹取》女主人公向第1个求婚者石作皇子提出的难题是去天竺取佛前的石钵,皇子却从附近大和国某山寺取来假钵代替,被识破;《斑竹姑娘》女孩子主人公向第1个求婚者土司儿子提出的难题是到缅甸去取撞不破的金钟,土司儿子却从古庙中偷来铜钟代替,被识破。
《竹取》女主人公向第2个求婚者车持皇子提出的难题是到东海蓬莱山取银根金茎白玉果树枝,皇子却派工匠偷偷假造玉枝欺骗姑娘,最后工匠来索取赏金,事败露;《斑竹姑娘》女主人公向第2个求婚者商人儿子提出的难题是到通天河取来打不碎的玉树,商人儿子却召来汉人工匠偷偷假造玉树欺骗姑娘,最后玉石匠来索取工钱,事败露。
《竹取》女主人公向第3个求婚者右大臣阿倍提出的难题是取来烧不着的火鼠皮裘,右大臣买来的皮裘用火一烧便成灰了;《斑竹姑娘》女主人公向第3个求婚者官吏儿子提出的难题是取来烧不着的火鼠皮袄,官吏儿子买来的皮袄一见火便烧成了灰。
《竹取》女主人公向第4个求婚者大伴大纳言提出的难题是取来海龙颈上的五色珠,他先用财物派人去取,人们骗取财物没去,他便亲自乘船去取,遇到暴风雨,险些丧生,飘回本土;《斑竹姑娘》女主人公却是向第5个求婚者胆小好吹牛的少年提出的难题是取来海龙颈下的分水珠,这少年先用武器财物派人去取,人们骗取财物没去,他亲自乘船去取遇到暴风雨,险些丧生,飘往南海孤岛。
《竹取》女主人公向第5个求婚者石中上纳言提出的难题是取来燕窝中的子安贝,中纳言乘筐子上房查看燕窝,从高处摔下来受伤;《斑竹姑娘》女主人公则是向第4个求婚者傲慢少年提出的难题是取来燕窝中的金蛋,少年乘桶到高楼上查看燕窝,从高处摔下来身死。

至于蘑菇,这捏他已经烂了,是藤原不比等(车持皇子,造了玉枝不给钱那主)的女儿,之前已经吐槽过典故和设定,这里就不再赘述了。
之所以萌蘑菇和NEET,基本理由大概是和NEET与师匠的CP是一样的。这几对都是不老不死,在这永恒之中,自然也只有这几位才能成为真正的陪伴。和师匠与NEET之间主仆情分一样,蘑菇和NEET之间持续千年的仇恨,同样能激发创作者们的激情。
仇恨比爱更持久。痛苦的回忆其实更容易进驻我们的脑海。这其实是因为生物学的原理,为了能够躲避下一次的悲惨,痛苦的回忆其实会起到更大的作用,可以作为经验教训铭记;而幸福不过是一种享乐。从进化角度讲,人怎么也应该多记一点被狮子挠老虎咬熊扑狼顶老鹰叼的记忆,以防着下次犯同样的错误;至于今天吃到多少烤肉找到多少山洞,这个倒不是特别重要。
估计是当时设计猴子的时候也没想到它们能进化成现在这样,这可就坑了智人。好多人之所以老觉得自己的生活很不幸,那真得怪老祖宗当年赖以求生的本能。不过反过来讲,仇恨的持久的确是长得惊人。老说君子报仇十年不晚,至于结婚的时候刚“七年”就开始“痒”。
所以蘑菇和辉夜,永远的生命,如果两人之间是爱的话,得多痒啊。
不是不能理解对方的立场,而是不愿理解对方的立场。我自己看一眼夜空,看到满天的星星,就开始眩晕:你说这么多的星星,存在了那么久,现在还存在,将来也将存在下去;这宇宙从创生到结束,可以说是世界上真正的“永恒”了,到底为了啥?短暂的生命里,短暂的人类的生命里,我们大可以说是为了追寻爱情的踪影,为了追赶自由的脚步,为了找寻幸福的真谛,乃至于为了全人类的福祉。然而随着时间尺度逐渐地拉长,存在的意义就逐渐地模糊。你说太阳存在的意义,难道是为了照耀人类?银河存在的意义,难道是为了隔开牛郎织女?宇宙的意义,难道是为了等待有那么一种生命能进化到足够聪明以至于给自己一个专门的称呼?还是说,一切不过是在大范围统计下的近似有序,实质不过是一坨坨的混乱?如果说最终的宇宙就是宇宙的意义,那么热力学定理指定时间一直向熵增方向流动,那个热寂而无限混乱的宇宙就是我们的意义。
那就是无意义。信我的,那真TM是无意义啊……
然而你要是让一个人无意义地活下去,那就真活不下去了。活不下去还可以自杀嘛。但是对于悲惨的NEET和蘑菇,连自杀都不行。想想海因莱因老大那本《时间足够你爱》,拉萨路不过2000岁就已经十分想自杀了;哥们,咱这俩是永远也死不了啊……时间已经足够我爱,但是我自己已经没有爱的兴致了。对于那个永恒的陪伴者,唯一能够永远不过期的感情,那就是恨。
所以蘑菇能爱老师,因为老师会死;而蘑菇要恨辉夜,因为蘑菇要活着,正如辉夜之所以恨妹红是因为辉夜也要活着。爱是一种责任,恨则是一种权利。
让她们恨下去吧。无论如何,这是真正能存在的意义,总好过在无尽的宇宙里迷失,不知道自己应该干什么。

(……至于为什么辉夜会爱师匠,我也不知道……)
如果不出意外的话,永夜抄的CP我就写到这里了。……之所以不写师匠是因为伦家看SAM神的视频太多,其他还好,只是对师匠的猎奇舞姿实在是不能忍,再加上我对师匠衣着风格的极度不以为然,我就把师匠跳了,各位如有兴致,自行处理吧……
永夜抄对于我个人来讲有着特别的回忆,我最早接触的东方便是永夜抄。当时北京市计算机竞赛的冬令营里面风靡永夜抄,一时间打压星际魔兽,几乎成了省队的专用游戏。我还记得刘汝佳大牛当年还写过一个“汝佳版永夜抄”……而且我去加拿大竞赛的时候,发现那边的竞赛选手也在玩东方……当时哥们还指着我说特高兴地说“another PCB player!”,一个劲问我“have you ever played IN?”……而我是在回来的飞机时才想起来PCB=perfect cherry blossom,IN=imperishable night……
所以顺便统计一下,有多少计算机竞赛的选手现在在这里混?
|